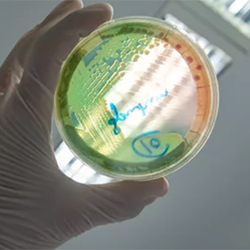

In a world of antimicrobial overuse, multidrug-resistant organisms, and many efforts toward stewardship, are the newer agents on the market being used appropriately?

Yes, according to one medication-use evaluation project by pharmacists at Banner University Medical Center, in Phoenix. They determined that use of the antibiotic cefiderocol (Fetroja, Shionogi) was largely appropriate and reserved for high-risk, multidrug-resistant gram-negative organisms per hospital policy. The work was presented in a poster (abstract P1183) at IDWeek 2025, in Atlanta, and published in Infectious Disease Reports (2025;17[5]:112).
Monitoring Local Microbes
Pharmacists with the hospital do these projects annually. The researchers chose to explore cefiderocol because its use had been gradually increasing over the past several years, study co-author Emir Kobic, PharmD, BCIDP, an antimicrobial stewardship and infectious disease pharmacist at the Arizona hospital, told Infectious Disease Special Edition.
In the hospital’s local area, Klebsiella pneumoniae carbapenemase (KPC) has been decreasing while New Delhi metallo-beta-lactamase (NDM) has been increasing; therefore, ceftazidime-avibactam (Avycaz, AbbVie) was less effective against the type of carbapenem-resistant Enterobacterales (CRE) seen. In its place, cefiderocol use has been growing.
Dr. Kobic and colleagues conducted a retrospective chart review of 76 hospitalized patients receiving at least one dose of cefiderocol from January 2023 to July 2024. They evaluated patients for clinical appropriateness of cefiderocol use, timing of initiation, microbiological susceptibilities, and outcomes including 30-day mortality, reinfection, and readmission.
The median patient age was 60 years, and they mainly identified as males (62%) and white (75%). Sites of infection included the urinary tract, bacteremia, skin and soft tissue, and respiratory. Of the patients, 48 (63%) had CRE, 13 (17%) had difficult-to-treat Pseudomonas aeruginosa, and nine (12%) had carbapenem-resistant Acinetobacter baumannii (CRAB) complex infections. They also included three patients with Stenotrophomonas. Some patients were positive for multiple organisms.
Cefiderocol was used primarily for CRE (63%) and CRAB (12%) infections. Most patients (96%) met the hospital’s restriction criteria. Cefiderocol was used as definitive therapy in 68% of cases, with a median initiation time of three days post-culture. The infectious diseases service was consulted in 99% of cases.
Empiric use was relatively common, at 32%, and 40% of patients had a history of multidrug-resistant organisms, he said.
Susceptibility Testing
Carbapenemase screening was performed using the NG-Test CARBA 5 assay (Hardy Diagnostics), which was run whenever an Enterobacterales was non-susceptible to any carbapenem. The rapid diagnostic test detects the presence of KPC, NDM, VIM (Verona Integron-encoded metallo-beta-lactamase), IMP (active against imipenem), and OXA-48. Screening was implemented at the hospital in November 2023, and results therefore were available only for patients admitted after this period. Some 77% of the bacteria tested had NDM. Susceptibility to cefiderocol in CRAB infections was only 50%—a steep decline compared with what previous research had shown (Antimicrob Agents Chemother 2022;66[2]:e0199021; Microbiol Spectr 2022;10[2]:e0271221), Dr. Kobic said.
Overall, 30-day mortality was 20% but 33% in CRAB infections, consistent with findings of the CREDIBLE-CR trial (Lancet Infect Dis 2021;21[2]:226-240). For those patients, clinicians followed guidelines to use cefiderocol in combination with another active agent, Dr. Kobic said. Susceptibility to cefiderocol was confirmed in 86% of organisms tested.
Identifying Delays
The team identified delays in susceptibility testing and inconsistent reporting of preferred agent susceptibilities. Delayed initiation of the drug—a median of three to five days, often beyond the 48- to 72-hour window studied in clinical trials—may have contributed to worse outcomes, particularly in CRAB infections, he said.
The project helped the investigators push for rapid diagnostics at the hospital, which will be incorporated starting in the first quarter of 2026, Dr. Kobic said.
Dr. Kobic reported receiving honoraria from Shionogi.